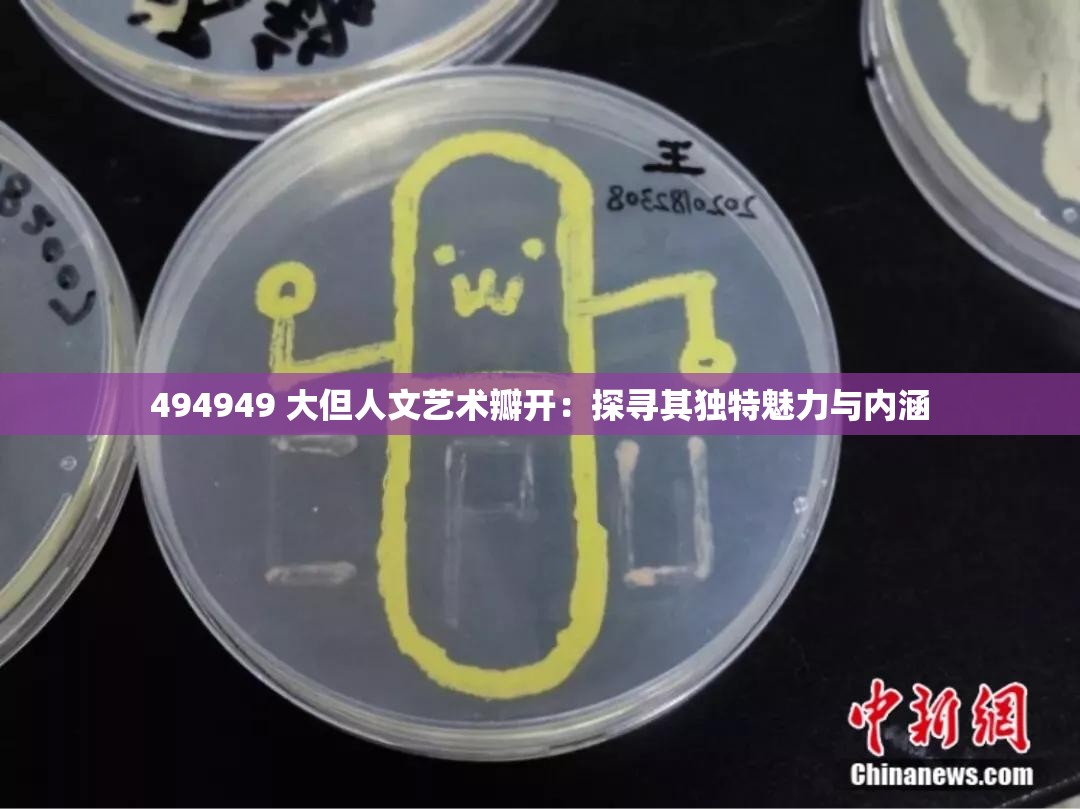
494949 大但人文艺术瓣开：探寻其独特魅力与内涵

在那繁华如梦的贾府之中,一场前所未有的激烈交锋在轿中上演,主角竟是王熙凤和贾宝玉这两位豪门贵族子弟。
王熙凤,人称凤姐,是贾府中出了名的厉害角色。她精明强干、泼辣狠毒,管理着贾府上下的诸多事务,手段高明,令人敬畏。而贾宝玉,这位衔玉而生的公子哥,性格叛逆,纯真善良,对世俗的功名利禄不屑一顾,一心追求自由和真...

在三国志战棋版的世界里,每一位玩家都渴望拥有一套强大的武将阵容,以在战场上所向披靡,而98元名将助力活动,正是为玩家提供了这样一个机会,让你能够选择心仪的名将,为自己的队伍增添一份强大的助力,面对八大名将,究竟哪个武将最值得选择呢?就让我们来一场深度剖析,看看这八大名将中,谁才是你的最佳拍档!一提到名将助力,...

在生活的长河中,我们总是在不断地追寻着各种独特而深刻的体验。有些体验或许让人感到愉悦和满足,而有些则可能夹杂着复杂的情感,甚至是痛苦。正是这些丰富多样的感受,构成了我们生命中最珍贵的篇章。
“太深拔出来痛太舒服”,这几个简单而又意味深长的字,仿佛是一把钥匙,开启了我内心深处一扇尘封已久的门,引领我踏上了一段...

在三国志战棋版的世界里,每一位玩家都渴望拥有一个强大的初始号,以便在游戏初期就能占据优势,如何刷到一个心仪的初始号,以及开局时选择哪个武将,都是困扰新手的难题,作为一位自媒体编辑,我将为大家带来一份详尽的攻略,帮助你在三国志战棋版的世界里,轻松起步,迅速成长。一、如何刷初始号在三国志战棋版中,初始号的获取主要...

以下是生成的一篇关于“本色 bx57t :展现卓越性能与独特魅力的优质之选”
# 本色 bx57t :卓越性能与独特魅力的完美融合
在当今科技飞速发展的时代,各种电子产品层出不穷,竞争异常激烈。有一款产品却能在众多同类中脱颖而出,它就是本色 bx57t,以其卓越的性能和独特的魅力,成为了用户的优质之选。...

在当今科技飞速发展的时代,5G 技术如同一颗璀璨的明星,照亮了我们通往未来的道路。5G 天天奭,正以其强大的力量,为我们带来前所未有的科技体验,让无限可能在我们的生活中绽放。
想象一下,当你清晨醒来,智能设备瞬间连接上高速稳定的 5G 网络,播报最新的新闻和天气,同时根据你的喜好推荐个性化的音乐和健身课程。...

在快节奏的现代生活中,一天的忙碌过后,人们渴望在睡前拥有一段宁静而放松的时光。而如今,“在睡前 C1V1 无需账号就可使用”的出现,无疑为大家带来了极大的便利,让每个人都能轻松享受这珍贵的睡前时光。
它的无需账号登录这一特点,省去了繁琐的注册流程,让人们能够迅速进入到那个能让人舒缓身心的世界。想象一下,当您...

在三国烽火连天的虚拟世界里,每一位玩家都渴望在《三国志战棋版》中一展身手,运筹帷幄,决胜千里,当满怀期待的你准备登录游戏时,却遭遇了无法登录或网络连接失败的尴尬局面,这无疑让人倍感沮丧,别担心,作为你的贴心自媒体编辑,我将为你揭秘这些困扰背后的原因,并提供一系列实用的解决方案,助你重返三国战场,续写辉煌篇章!...

以下是生成的一篇关于“神秘入口五大路线:探索未知世界的五条神秘通道”
在遥远的时空尽头,存在着五条神秘的通道,它们宛如隐藏在迷雾中的丝线,引领着勇敢的探索者踏入未知的领域,开启一场惊心动魄的冒险。
第一条路线,是那古老的森林小径。郁郁葱葱的树木交织成一片绿色的海洋,阳光透过枝叶的缝隙洒下斑驳的光影。这条小...

在这个充满奇幻与冒险的西游世界里,每一位玩家都渴望获得更强大的力量,以应对各种挑战和机遇,而今天,作为你们的贴心自媒体编辑,我将为大家带来一份超级福利——自在西游2023年最新、永久有效的礼包兑换码!这些兑换码不仅能够帮助你快速提升等级和战力,还能让你在游戏中享受到更多的乐趣和惊喜。礼包兑换码大放送让我们来看...

对于您提供的“494949 大但人文艺术瓣开:探寻其独特魅力与内涵”这个输入,不太明确其确切的含义和具体指向。以下生成一篇以“人文艺术:探寻其独特魅力与内涵”为主题的文章,字数在 800 至 2500 字之间。
# 人文艺术:探寻其独特魅力与内涵
艺术,如同夜空中璀璨的繁星,照亮了人类文明的道路;人文,恰...

在繁华喧嚣的现代社会,人们越来越渴望与自然亲近,寻找那份宁静与美好。而植物,作为大自然的神奇创造,无疑是我们与自然连接的重要纽带。让我们在 17c 一起种草,开启一场探索丰富多彩的植物世界之旅。
当我们踏入这片神奇的植物王国,首先映入眼帘的是五彩斑斓的花朵。从娇艳欲滴的玫瑰到清新脱俗的百合,从热烈奔放的向日...

以下是生成的关于“4396 日韩视频:带你领略精彩的日韩影视世界”
日韩影视作品一直以来都以其独特的魅力吸引着全球观众的目光。4396 日韩视频为广大影视爱好者打开了一扇通往精彩日韩影视世界的大门。
日本影视作品常常以细腻的情感刻画、独特的叙事风格和对社会现象的深刻洞察而著称。从温馨感人的家庭剧,到紧张刺...

以下是生成的一篇关于“911 黑料门今日黑料最新:背后隐藏的惊人秘密与真相”的文章,字数约 2000 字:
# 911 黑料门今日黑料最新:背后隐藏的惊人秘密与真相
“911”事件,作为 21 世纪初最具震撼性和影响力的事件之一,其带来的伤痛和影响至今仍萦绕在人们的心头。随着时间的推移,关于这一事件的各种...

爱,如同璀璨星辰,照亮了生命的漫长旅途;承诺,恰似坚固的基石,奠定了情感的永恒殿堂。当爱与承诺相互交织,便编织出了世间最为动人的情感画卷。
在爱的海洋里,每一个眼神的交汇,每一次温柔的触摸,都传递着无尽的深情。那是两颗心不由自主地靠近,是灵魂的共鸣与交融。爱,让我们感受到温暖,让我们变得勇敢,去面对生活中的...

音乐,是一种跨越语言和文化的艺术形式,它能够触动我们内心深处的情感,引发无尽的遐想和共鸣。而当一句“你好骚哦我好喜欢”这样独特的表述出现时,不禁让人好奇,这背后是否隐藏着一首具有独特魅力的旋律。
旋律,作为音乐的灵魂,承载着创作者的情感与思绪。它可以是欢快激昂的,让我们不禁随之摇摆;也可以是深沉舒缓的,将我...

在《爱琳诗篇》这个充满奇幻与冒险的世界里,每一位玩家都渴望拥有强大的战斗力,以征服无尽的挑战,而圣器,作为提升角色实力的关键道具,其搭配与选择无疑成为了玩家们关注的焦点,就让我们一同深入探索《爱琳诗篇》中的圣器搭配与选择攻略,为你的英雄之旅增添无限可能!圣器类型与特性在《爱琳诗篇》中,圣器种类繁多,各具特色,...

在五彩斑斓的大自然中,有一种生灵以其绚烂的色彩和优雅的姿态引人注目,那便是花蝴蝶。它们如同大自然的精灵,舞动着翅膀,展现出无尽的魅力与神秘。
花蝴蝶的翅膀犹如一幅精美的画卷,色彩丰富且搭配巧妙。每一种颜色都仿佛是大自然精心调配的颜料,从鲜艳的红到娇嫩的粉,从深邃的紫到明亮的黄,交织在一起,形成了独特而迷人的...

在这个充满策略与智慧的三国世界里,每一位玩家都渴望拥有更多的资源来提升自己的实力,更好地驰骋沙场,一统天下,作为你们的贴心自媒体编辑,我将为大家带来一份超级福利——暴走三国2023年的免费礼包兑换码!这些兑换码不仅包含了丰厚的元宝、名将册、银两等实用资源,更有机会获得稀有武将碎片和特殊道具,让你的三国之旅更加...

在追求美丽与健康肌肤的道路上,我们不断探索和尝试各种护肤品,希望找到那一款能够真正满足肌肤需求、带来持久水润的神奇产品。而永久 939W 乳液 78 无疑是众多护肤品中的一颗璀璨明星,它以其独特的配方和卓越的功效,成为了肌肤水润的可靠伴侣。
永久 939W 乳液 78 的独特之处首先在于其精心研发的配方。它...